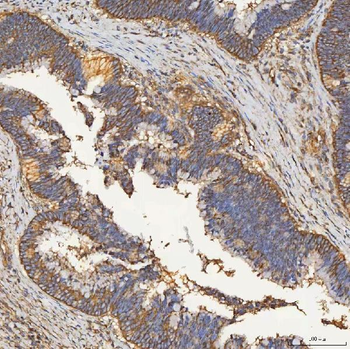
SEC23IP Antibody
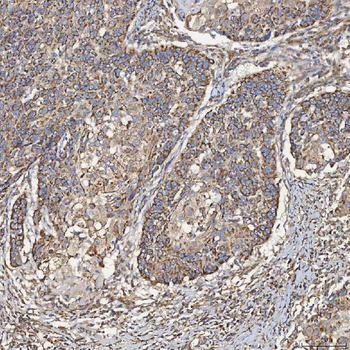
SEC23IP Antibody
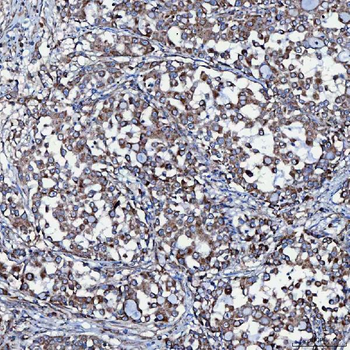
SEC23IP Antibody
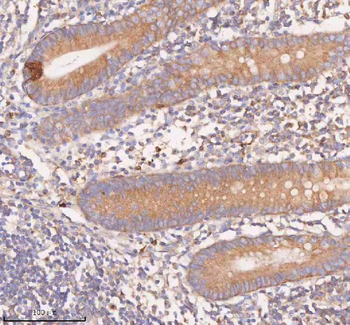
SCAMP3 Antibody
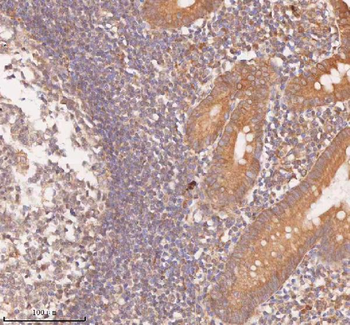
SAMD9L Antibody
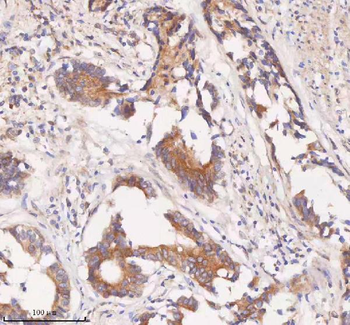
SAMD9L Antibody

You have no items in your shopping cart.
All Products
- NKp46 antibody [orb13333]Featured

ICC, IF, IHC-P, WB
Human, Mouse, Rat
Rabbit
Polyclonal
Unconjugated
100 μg - LHCGR antibody [orb13542]Featured

ICC, IF, IHC-P, WB
Human, Mouse, Porcine, Rat
Rabbit
Polyclonal
Unconjugated
100 μg - SEC23IP Antibody [orb1402107]
ELISA, FC, ICC, IF, IHC, WB
Human, Monkey, Mouse, Rat
Rabbit
Polyclonal
Unconjugated
100 μg - ASGR1 Rabbit Polyclonal Antibody [orb574829]
WB
Human
Bovine, Equine, Guinea pig, Mouse, Porcine, Rat, Yeast
Rabbit
Polyclonal
Unconjugated
100 μl - ASGR1 Rabbit Polyclonal Antibody [orb574828]
WB
Human
Bovine, Equine, Guinea pig, Mouse, Porcine, Rat, Yeast
Rabbit
Polyclonal
Unconjugated
100 μl - BDNF Rabbit Polyclonal Antibody [orb578294]
IHC, WB
Human, Monkey, Mouse
Canine, Equine, Porcine, Rabbit, Rat
Rabbit
Polyclonal
Unconjugated
100 μl - ARS2/SRRT Antibody [orb1676512]
ELISA, FC, ICC, IF, IHC, IP, WB
Human, Mouse, Rat
Rabbit
Polyclonal
Unconjugated
100 μg - SCAMP3 Antibody [orb1939911]
ELISA, FC, ICC, IF, IHC, WB
Human, Rat
Rabbit
Polyclonal
Unconjugated
100 μg